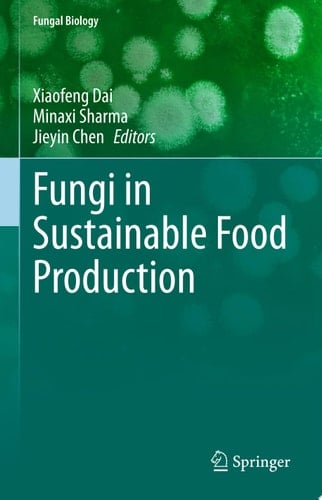
Fungi in Sustainable Food Production

This book presents research on the challenges and potential of fungal contribution in agriculture for food substantiality. Research on fungi plays an essential role in the improvement of biotechnologies which lead global sustainable food production. Use of fungal processes and products can bring increased sustainability through more efficient use of natural resources. Fungal inoculum, introduced into soil together with seed, can promote more robust plant growth through increasing plant uptake of nutrients and water, with plant robustness being of central importance in maintaining crop yields. Fungi are one of nature′s best candidates for the discovery of food ingredients, new drugs and antimicrobials. As fungi and their related biomolecules are increasingly characterized, they have turned into a subject of expanding significance. The metabolic versatility makes fungi interesting objects for a range of economically important food biotechnology and related applications. The potentialof fungi for a more sustainable world must be realized to address global challenges of climate change, higher demands on natural resources.
Page Count:
234
Publication Date:
2021-04-06
ISBN-10:
3030644065
ISBN-13:
9783030644062
No comments yet. Be the first to share your thoughts!